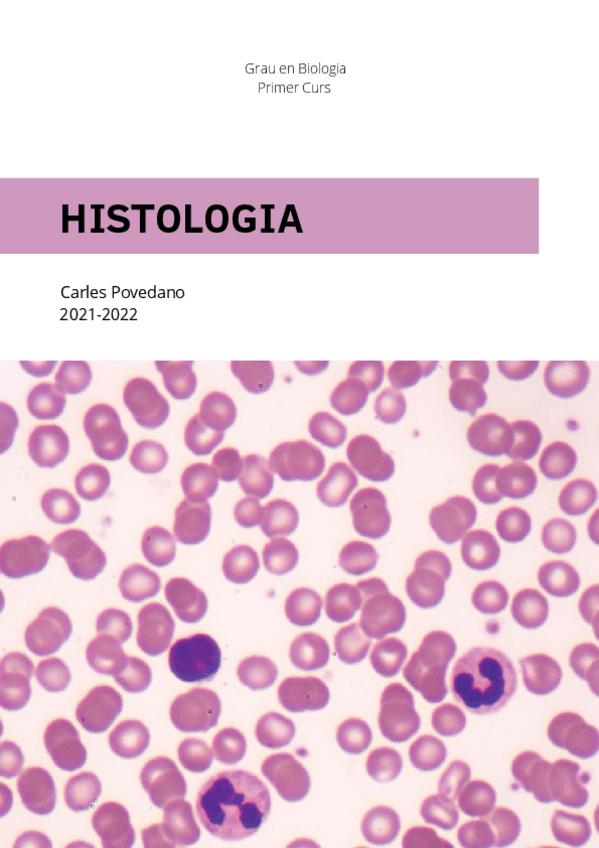

@carless03
65 Publicaciones
4.54k Interacciones
35 Seguidores
16 Siguiendo
Lista de publicaciones de carless03
apuntes
-
apunts FA 22/23
He publicado nuevos apuntes de 2º Fisiologia Animal: Sistemes: apunts FA 22/23
apuntes
-
nutri vegetal 22/23
He publicado nuevos apuntes de 2º Nutrició i Metabolisme Vegetal: nutri vegetal 22/23
apuntes
-
Apunts genètica molecular 22-23
He publicado nuevos apuntes de 2º Genética Molecular: Apunts genètica molecular 22-23
apuntes
-
Apunts Zoologia II (22-23)
He publicado nuevos apuntes de 2º Ampliació de Zoologia: Apunts Zoologia II (22-23)
apuntes
-
Apunts biocel 22-23
He publicado nuevos apuntes de 2º Ampliació de Biologia Cel·lular: Apunts biocel 22-23
apuntes
-
Zoologia Resums Ordres Insectes
He publicado nuevos apuntes de 2º Ampliació de Zoologia: Zoologia Resums Ordres Insectes
apuntes
-
Apunts i Visum Zoologia 21-22
He publicado nuevos apuntes de 1º Zoología: Apunts i Visum Zoologia 21-22
apuntes
-
Apunts Biologia Cel·lular 21-22
He publicado nuevos apuntes de 1º Biología Celular: Apunts Biologia Cel·lular 21-22
apuntes
-
Botànica Apunts i Seminaris 2021-2022
He publicado nuevos apuntes de 1º Botánica: Botànica Apunts i Seminaris 2021-2022
apuntes
-
Apunts EFB 2021-2022
He publicado nuevos apuntes de 1º Estructura i Funció de Biomolècules: Apunts EFB 2021-2022
apuntes
-
Apunts i visum Histo 21-22
He publicado nuevos apuntes de 1º Histología: Apunts i visum Histo 21-22
apuntes
-
BIOLOGIA PAU
He publicado nuevos apuntes de Biología: BIOLOGIA PAU